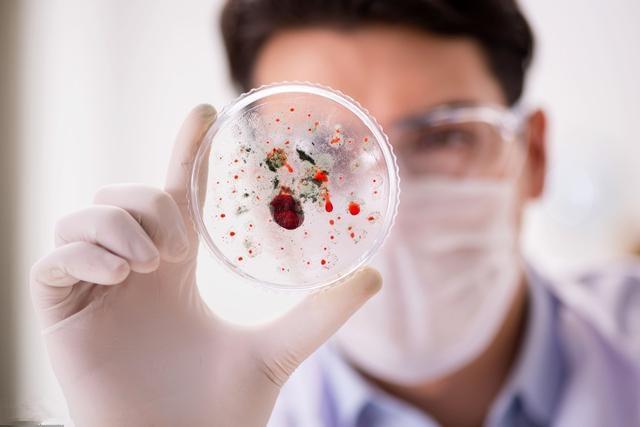
癌症患者补什么硒好呢(癌症患者补硒有用吗)-硒宝网

癌症患者补什么硒好呢(癌症患者补硒有用吗)
你相信吗?全世界所有癌症中大约1/3是吃出来的。此话并非这危言耸听,在最新医学研究表明,目前我国中老年患者中平均每4人就有1人患癌症,其中80%的肿瘤是由不良生活方式和环境因素所致,35%-40%的肿瘤发病与不科学、不合理的膳食习惯有关。所以,从现在开始,请控制好你的嘴!不要等到吃出癌症来了才后悔莫及。
许多癌症患者后悔当初吃了太多这3种食物,你可能每一个都在吃
1、吃了太多太咸的食物
如果减少食盐、盐腌制品,多吃新鲜蔬菜、水果,那么胃癌发病率就会下降。亚硝酸盐是导致肿瘤的第一杀手。不新鲜的蔬菜、腌制的火腿、泡菜都含有这种致癌物。通常条件下膳食中的亚硝酸盐不会对人体健康造成危害,只有过量摄入亚硝酸盐,体内又缺乏维生素C的情况下,才会对人体引起危害。如果吃的过咸,会破坏胃黏膜,促使硝酸盐还原成亚硝酸盐。

2、吃了太多油腻的食物
日常饮食补要过于油腻,调查显示,如果油、动物蛋白的摄入量增加,大肠癌、乳腺癌、前列腺癌、胰腺癌的发病率就会上升。高温煎炸食物会产生苯并芘、杂环胺类化合物和丙烯酰胺,与妇女肺腺癌可能相关,而水煮及微波炉蒸则不发生。

3、吃了太多烫嘴的食物
所谓的温热性食物,一是指直接感受到的温度过高、过烫的食品;一是指属于中医药性划分中的温热之性食物。因为过于辛热,容易损伤消化道黏膜上皮细胞,所以这类性质的食品最易诱发的是消化系统的肿瘤。

虽然这些饮食习惯吃一顿、两顿,不会给我们身体造成太大的危害,但是经过长时间的积累,最终就有可能导致癌症。因此,为了以后远离癌症,这2件事情必须马上做,让癌细胞离你远远地。
1、要养成补充硒元素的好习惯
硒元素最突出的功效就是能够提高人体免疫力、抑制癌细胞的再生、促使癌细胞的凋亡。现在临床医学中,很多情况下已经用硒来防癌、抗癌以及解除癌症病人的痛苦、延长癌症病人的生命。
同时硒元素还可以提高机体细胞免疫力,而免疫力下降是癌症发生、发展的重要的因素之一,而抗癌症免疫主要是细胞免疫,因此提高机体的细胞免疫功能十分重要。

补硒可以通过饮食补充,安全无副作用,比如饮用蒿坪绿茶,因产自有“中国硒谷”之称的陕西紫阳县蒿坪镇硒谷生态区而出名,每一公斤茶叶中富含150ug硒元素,是一般绿茶的6倍还多,每次3-5g蒿坪绿茶,可有效补充人体每日所需硒元素。
2、养成每天都出点汗的好习惯

运动是最经济实惠的防癌方法。经常锻炼的人患肺癌风险可降低68%,患结直肠癌风险直降38%,只要每天坚持30分钟以上运动,就能降低患癌风险,运动时出汗,既能燃烧多余脂肪,还可促进身体排出多种致癌物
